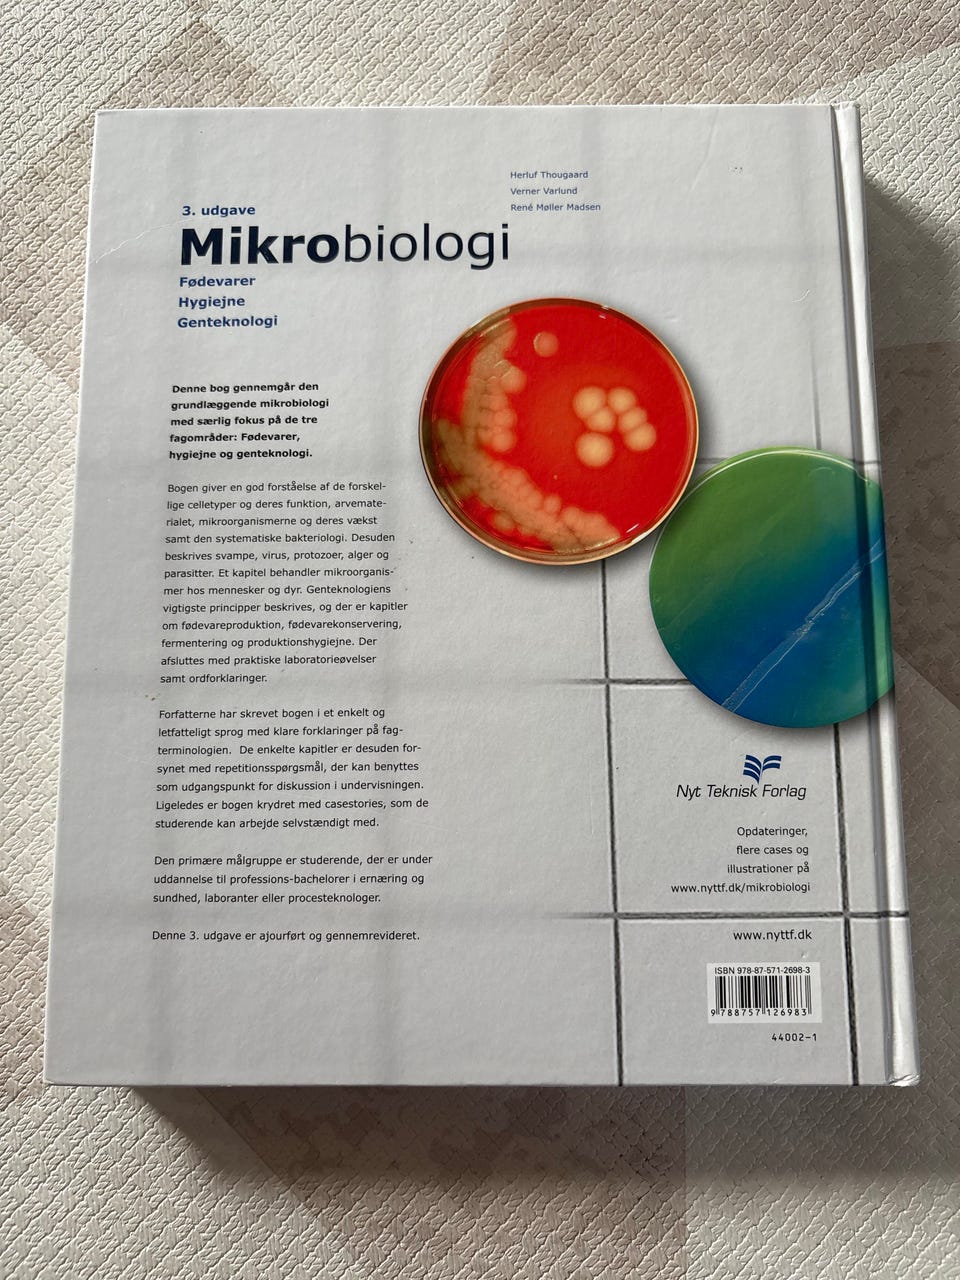
Galleribillede

Billedgalleri
(1/4)
Mikrobiologi lærebog Biologi
Til salg
Fiks færdig
50 kr.
Fragt fra 39,99 kr. + Tryg betaling 12 kr.
Tryg handel med Fiks færdig
Fiks færdig er DBA's nye betalings- og fragttjeneste. Efter levering har du 24 timer til at kontrollere varen, før pengene udbetales til sælgeren.
Varebeskrivelse
Stand: Som ny - ingen synlige brugsspor
Emne: Biologi
Mikrobiologi lærebog til biologifaget, 3. udgave, 2. oplag fra 2011. Indeholder emner som fødevarer, hygiejne og genteknologi. Bogen er trykt på Arctic Matt 100 papir og indeholder 16 sider med Minion Pro og Formata skrifttyper. ISBN-13: 978-87-571-2698-3.
Brugt på uddannelsen Ernæring & Sundhed.
Brugt meget sparsomt.
Ingen overstregninger.
Bemærk: Knappen til at vise den fulde beskrivelse har kun en visuel effekt.
Brugerprofil

Du skal være logget ind for at se brugerprofiler og sende beskeder.
Log indAnnoncens metadata
Sidst redigeret: 15.3.2026 kl. 10:00 ・ Annonce-ID: 17021236